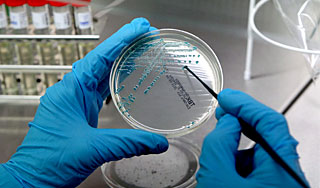
Смертельную E. coli ищут в питьевой воде Смертельную E. coli ищут в питьевой воде

10 октября, четверг | ![]() ![]() ![]() |
![]() | ПОЛИТИКА | ЭКОНОМИКА | ОБЩЕСТВО | ПРОИСШЕСТВИЯ | КУЛЬТУРА | СПОРТ | МЕДИА | В МИРЕ | АВТО | ТЕХНОЛОГИИ | ![]() |
| Фоторепортажи | Видеосюжеты | Комментарии | Погода | Работа | Форум | Карта | Подписка и RSS | Реклама| О газете |
Смертельную E. coli ищут в питьевой воде26 июня 2011, воскресенье, 16:05 – БРЯНСК.RU | Комментарии: 0
| Версия для печати Бактерия – возбудитель кишечной инфекции, от которой в Германии скончались более 40 человек, может находиться в питьевой воде. Эксперты заявили, что возбудитель, найденный в водоеме недалеко от Франкфурта-на-Майне, мог попасть в водопровод."Мы не исключаем, что бактерия уже "окопалась" в окружающей нас среде, – отметил директор Института гигиены университетской клиники в Мюнстере Хельге Карх. – Она приспосабливается и может вновь попадать к людям". Особенно опасно попадание возбудителя в водопроводную систему в сельской местности, где качество воды проверяется гораздо реже, нежели в областях с высокой плотностью населения. "Опасность заражения питьевой воды абсолютно недооценивается", – отметил в свою очередь Мартин Экснер, директор боннского Института гигиены в университетской клинике и одновременно председатель комиссии Федерального ведомства по охране окружающей среды. Так, согласно исследованию, проведенному Всемирной организацией здравоохранения, в земле Баден-Вюртемберг в пяти процентах проб питьевой воды из небольших водопроводных систем и в воде из каждого второго частного колодца содержатся кишечные бактерии, сообщают "Вести.Ru". В настоящее время число жертв кишечной палочки E. coli в Европе достигло 43 человек. Один летальный исход зарегистрирован в Швеции, все остальные – в Германии. 850 человек находятся в тяжелом состоянии. Накануне власти Франции запретили продажу злаков британского производителя из-за штамма E. coli. Французские санитарные власти получили информацию о шести случаях кровавой диареи и двух случаях гемолитико-уремического синдрома, зафиксированных в районе Бордо на юго-западе страны. В связи с подозрением группового отравления было принято решение о госпитализации семи человек. Двое госпитализированных в Бордо французов находятся в реанимации. Состояние одной из них, 78-летней женщины, ухудшается, вторая идет на поправку, передает РИА Новости. По словам госсекретаря по торговле Фредерика Лефевра, специалистам удалось установить, что люди могли отравиться на ярмарке в местечке Бегль в пригороде Бордо. Причиной заражения могли стать пажитник, горчица, и руккола британского производителя. Источник:
|
![]() | ПОЛИТИКА | ЭКОНОМИКА | ОБЩЕСТВО | ПРОИСШЕСТВИЯ | КУЛЬТУРА | СПОРТ | МЕДИА | В МИРЕ | АВТО | ТЕХНОЛОГИИ | ![]() |
| Фоторепортажи | Видеосюжеты | Комментарии | Погода | Работа | Форум | Карта | Подписка и RSS | Реклама| О газете |
| Размещение рекламы в газете БРЯНСК.RU: Прайс-лист, тел. (4832) 37-19-38, почта info@briansk.ru Для информационных писем в редакцию: news@briansk.ru | ![]() | ![]() | ||
| 2005–2015 © Ежедневная интернет-газета БРЯНСК.RU При цитировании активная ссылка на БРЯНСК.RU обязательна Материалы газеты могут содержать информацию 18+ | ![]() | Открыв данный сайт, Вы соглашаетесь с Правилами cайта (договор-оферта). Если вы не согласны с Правилами, немедленно покиньте сайт! | ![]() |

В глубине экрана: Мастер-класс по ремонту телевизоров
Погружение в мир футбола онлайн: для поклонников Игры
Займ без проверок
Тотализаторы: что это такое и чем они отличаются от обычных ставок?
Играть в бесплатные игровые автоматы в онлайн-клубе Вулкан
Стоит ли посещать офтальмолога при замене очков?
Успешные игроки предпочитают игровые автоматы Вулкан
Новое казино Супер Слотс поможет воплотить ваши мечты в реальность







ПОПУЛЯРНЫЕ МАТЕРИАЛЫ










